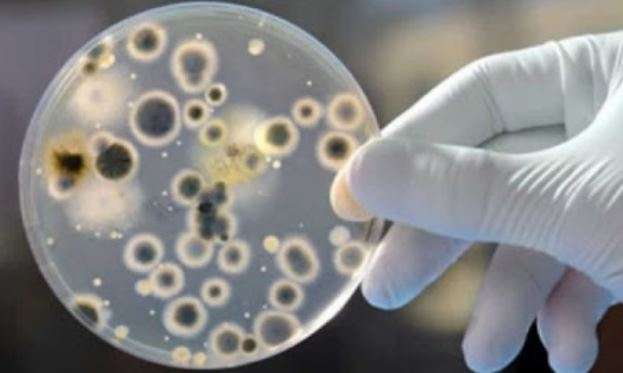

Regiaonline Há 5 anos
Regiaonline Plantão Coronavírus: Em Glória de Dourados, mais 01 paciente vai para UTI, ativos saltam para 48 e suspeitos são 30.
Regiaonline Plantão Coronavírus: Em Glória de Dourados, mais 01 paciente vai para UTI, ativos saltam para 48 e suspeitos são 30.